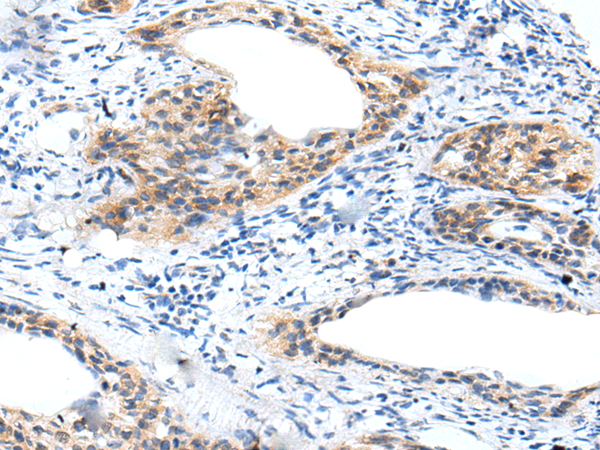

|
Background: |
Hyaluronidase degrades hyaluronic acid, a major structural proteoglycan found in extracellular matrices and basement membranes. Six members of the hyaluronidase family are clustered into two tightly linked groups on chromosome 3p21.3 and 7q31.3. This gene was previously referred to as HYAL1 and HYA1 and has since been assigned the official symbol SPAM1; another family member on chromosome 3p21.3 has been assigned HYAL1. This gene encodes a GPI-anchored enzyme located on the human sperm surface and inner acrosomal membrane. This multifunctional protein is a hyaluronidase that enables sperm to penetrate through the hyaluronic acid-rich cumulus cell layer surrounding the oocyte, a receptor that plays a role in hyaluronic acid induced cell signaling, and a receptor that is involved in sperm-zona pellucida adhesion. Abnormal expression of this gene in tumors has implicated this protein in degradation of basement membranes leading to tumor invasion and metastasis. Multiple transcript variants encoding different isoforms have been found for this gene. |
|
Applications: |
ELISA, IHC |
|
Name of antibody: |
SPAM1 |
|
Immunogen: |
Synthetic peptide of human SPAM1 |
|
Full name: |
sperm adhesion molecule 1 (PH-20 hyaluronidase, zona pellucida binding) |
|
Synonyms: |
HYA1; PH20; HYAL1; HYAL3; HYAL5; PH-20; SPAG15; HEL-S-96n |
|
SwissProt: |
P38567 |
|
ELISA Recommended dilution: |
5000-10000 |
|
IHC positive control: |
Human cervical cancer |
|
IHC Recommend dilution: |
10-50 |
購物車
購物車 幫助
幫助
 021-54845833/15800441009
021-54845833/15800441009
